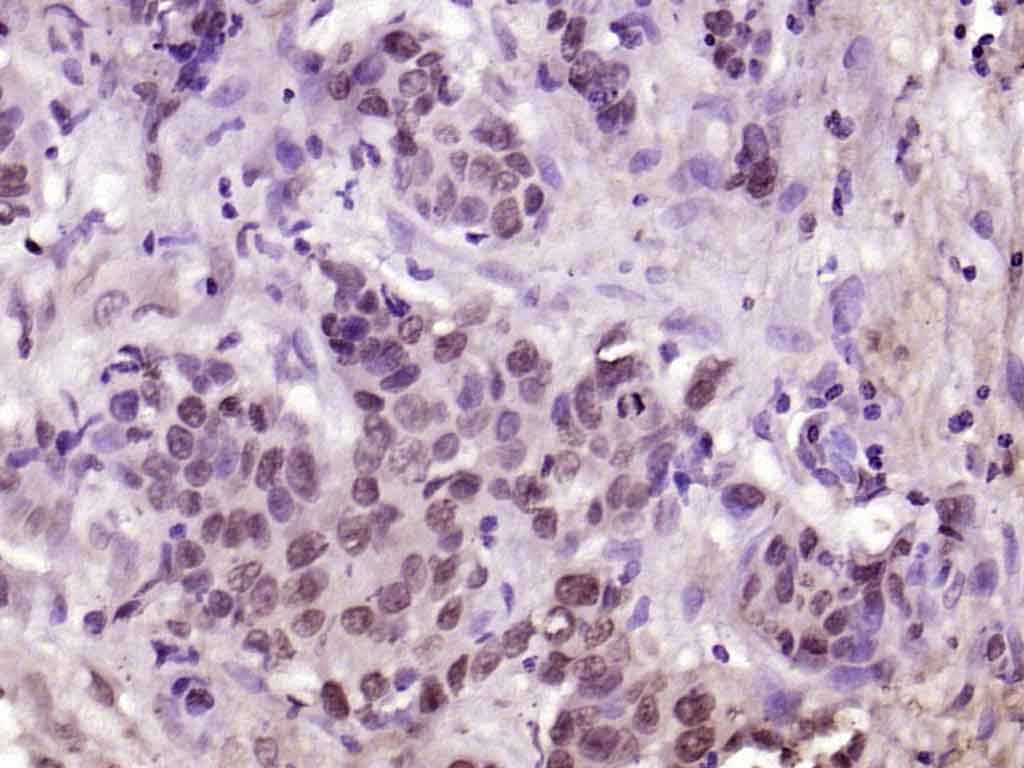

购物车
 您的购物车当前为空
您的购物车当前为空
Anti-Phospho-YAP1 (Tyr407) Polyclonal Antibody 是一种 Rabbit 抗体,靶向 Phospho-YAP1 (Tyr407)。Anti-Phospho-YAP1 (Tyr407) Polyclonal Antibody 可用于 IF,IHC-Fr,IHC-P,WB。
别名 Yes-associated protein YAP65 homolog, YAP1-2delta, YAP1 (p-Y407), YAP1 (p-Tyr407), YAP1, Transcriptional coactivator YAP1, p-YAP1 (Y407), p-YAP1 (Tyr407), Protein yorkie homolog
Anti-Phospho-YAP1 (Tyr407) Polyclonal Antibody 是一种 Rabbit 抗体,靶向 Phospho-YAP1 (Tyr407)。Anti-Phospho-YAP1 (Tyr407) Polyclonal Antibody 可用于 IF,IHC-Fr,IHC-P,WB。
| 规格 | 价格 | 库存 | 数量 |
|---|---|---|---|
| 50 μL | ¥ 1,165 | 5日内发货 | |
| 100 μL | ¥ 1,970 | 5日内发货 | |
| 200 μL | ¥ 2,795 | 5日内发货 |
TargetMol的所有产品仅用作科学研究或药证申报,不能被用于人体,我们不向个人提供产品和服务。请您遵守承诺用途,不得违反法律法规规定用于任何其他用途。
| 产品描述 | Anti-Phospho-YAP1 (Tyr407) Polyclonal Antibody is a Rabbit antibody targeting Phospho-YAP1 (Tyr407). Anti-Phospho-YAP1 (Tyr407) Polyclonal Antibody can be used in IF,IHC-Fr,IHC-P,WB. |
| 别名 | Yes-associated protein YAP65 homolog, YAP1-2delta, YAP1 (p-Y407), YAP1 (p-Tyr407), YAP1, Transcriptional coactivator YAP1, p-YAP1 (Y407), p-YAP1 (Tyr407), Protein yorkie homolog |
| Ig Type | IgG |
| 反应种属 | Human,Mouse,Rat (predicted:Chicken,Dog,Pig,Cow,Horse,Rabbit) |
| 验证活性 | 1. Paraformaldehyde-fixed, paraffin embedded (rat stomach tissue); Antigen retrieval by boiling in sodium citrate buffer (pH6.0) for 15 min; Block endogenous peroxidase by 3% hydrogen peroxide for 20 min; Blocking buffer (normal goat serum) at 37°C for 30 min; Antibody incubation with (YAP1 (Tyr407)) Polyclonal Antibody, Unconjugated (TMAB-01532) at 1:400 overnight at 4°C, followed by operating according to SP Kit (Rabbit) instructionsand DAB staining. 2. Paraformaldehyde-fixed, paraffin embedded (Rat breast tissue); Antigen retrieval by boiling in sodium citrate buffer (pH6.0) for 15 min; Block endogenous peroxidase by 3% hydrogen peroxide for 20 min; Blocking buffer (normal goat serum) at 37°C for 30 min; Antibody incubation with (YAP1 (Tyr407)) Polyclonal Antibody, Unconjugated (TMAB-01532) at 1:400 overnight at 4°C, followed by operating according to SP Kit (Rabbit) instructionsand DAB staining. 3. Paraformaldehyde-fixed, paraffin embedded (Human esophageal cancer); Antigen retrieval by boiling in sodium citrate buffer (pH6.0) for 15 min; Block endogenous peroxidase by 3% hydrogen peroxide for 20 min; Blocking buffer (normal goat serum) at 37°C for 30 min; Antibody incubation with (Phospho-YAP1 (Tyr407)) Polyclonal Antibody, Unconjugated (TMAB-01532) at 1:200 overnight at 4°C, followed by operating according to SP Kit (Rabbit) instructionsand DAB staining. 4. Paraformaldehyde-fixed, paraffin embedded (human breast); Antigen retrieval by boiling in sodium citrate buffer (pH6.0) for 15 min; Block endogenous peroxidase by 3% hydrogen peroxide for 20 min; Blocking buffer (normal goat serum) at 37°C for 30 min; Antibody incubation with (Phospho-YAP1 (Tyr407)) Polyclonal Antibody, Unconjugated (TMAB-01532) at 1:200 overnight at 4°C, followed by operating according to SP Kit (Rabbit) instructionsand DAB staining. 5. Paraformaldehyde-fixed, paraffin embedded (human breast carcinoma); Antigen retrieval by boiling in sodium citrate buffer (pH6.0) for 15 min; Block endogenous peroxidase by 3% hydrogen peroxide for 20 min; Blocking buffer (normal goat serum) at 37°C for 30 min; Antibody incubation with (Phospho-YAP1 (Tyr407)) Polyclonal Antibody, Unconjugated (TMAB-01532) at 1:200 overnight at 4°C, followed by operating according to SP Kit (Rabbit) instructionsand DAB staining. 6. Sample: NIH/3T3 (Mouse) Cell Lysate at 30 μg Primary: Anti-Phospho-YAP1 (Tyr407) (TMAB-01532) at 1/1000 dilution Secondary: IRDye800CW Goat Anti-Rabbit IgG at 1/20000 dilution Predicted band size: 65-70 kDa Observed band size: 70 kDa 7. Sample: Hela (Human) Cell Lysate at 30 μg Hela-Uv (Human) Cell Lysate at 30 μg 293t (Human) Cell Lysate at 30 μg 293T-Uv (Human) Cell Lysate at 30 μg Primary: Anti-Phospho-YAP1 (Tyr407) (TMAB-01532) at 1/1000 dilution Secondary: IRDye800CW Goat Anti-Rabbit IgG at 1/20000 dilution Predicted band size: 65-70 kDa Observed band size: 70 kDa 8. Sample: Lung (Mouse) Lysate at 40 μg Lung (Rat) Lysate at 40 μg Primary: Anti-Phospho-YAP1 (Tyr407) (TMAB-01532) at 1/1000 dilution Secondary: IRDye800CW Goat Anti-Rabbit IgG at 1/20000 dilution Predicted band size: 65-70 kDa Observed band size: 70 kDa 9. Paraformaldehyde-fixed, paraffin embedded (human esophageal cancer); Antigen retrieval by boiling in sodium citrate buffer (pH6.0) for 15 min; Block endogenous peroxidase by 3% hydrogen peroxide for 20 min; Blocking buffer (normal goat serum) at 37°C for 30 min; Antibody incubation with (Phospho-YAP1 (Tyr407)) Polyclonal Antibody, Unconjugated (TMAB-01532) at 1:200 overnight at 4°C, followed by operating according to SP Kit (Rabbit) instructionsand DAB staining. 10. Paraformaldehyde-fixed, paraffin embedded (human lung carcinoma); Antigen retrieval by boiling in sodium citrate buffer (pH6.0) for 15 min; Block endogenous peroxidase by 3% hydrogen peroxide for 20 min; Blocking buffer (normal goat serum) at 37°C for 30 min; Antibody incubation with (Phospho-YAP1 (Tyr407)) Polyclonal Antibody, Unconjugated (TMAB-01532) at 1:200 overnight at 4°C, followed by operating according to SP Kit (Rabbit) instructionsand DAB staining. |
| 应用 | IFIHC-FrIHC-PWB |
| 推荐剂量 | WB: 1:500-2000; IHC-P: 1:100-500; IHC-Fr: 1:100-500; IF: 1:100-500 |
| 抗体种类 | Polyclonal |
| 宿主来源 | Rabbit |
| 亚细胞定位 | Cytoplasm. Nucleus. |
| 组织特异性 | Increased expression seen in some liver and prostate cancers. Isoforms lacking the transactivation domain found in striatal neurons of patients with Huntington disease (at protein level). |
| 构建方式 | Polyclonal Antibody |
| 纯化方式 | Protein A purified |
| 性状 | Liquid |
| 缓冲液 | 0.01M TBS (pH7.4) with 1% BSA, 0.02% Proclin300 and 50% Glycerol. |
| 浓度 | 1 mg/mL |
| 研究背景 | This gene encodes the human ortholog of chicken YAP protein which binds to the SH3 domain of the Yes proto-oncogene product. This protein contains a WW domain that is found in various structural, regulatory and signaling molecules in yeast, nematode, and mammals, and may be involved in protein-protein interaction. [provided by RefSeq]. |
| 免疫原 | KLH conjugated Synthesised phosphopeptide: human YAP around the phosphorylation site of Tyr407 |
| 抗原种属 | Human |
| 基因名称 | YAP1 |
| 基因ID | |
| 蛋白名称 | Transcriptional coactivator YAP1 |
| Uniprot ID | |
| 研究领域 | Signal transduction,Proto-oncogenes,Transcription Factors,Cytoplasmic,Src Family |
| 功能 | Transcriptional regulator which can act both as a coactivator and a corepressor and is the critical downstream regulatory target in the Hippo signaling pathway that plays a pivotal role in organ size control and tumor suppression by restricting proliferation and promoting apoptosis (PubMed:17974916, PubMed:18280240, PubMed:18579750, PubMed:21364637). The core of this pathway is composed of a kinase cascade wherein STK3/MST2 and STK4/MST1, in complex with its regulatory protein SAV1, phosphorylates and activates LATS1/2 in complex with its regulatory protein MOB1, which in turn phosphorylates and inactivates YAP1 oncoprotein and WWTR1/TAZ (PubMed:18158288). Plays a key role in tissue tension and 3D tissue shape by regulating cortical actomyosin network formation. Acts via ARHGAP18, a Rho GTPase activating protein that suppresses F-actin polymerization (PubMed:25778702). Plays a key role to control cell proliferation in response to cell contact. Phosphorylation of YAP1 by LATS1/2 inhibits its translocation into the nucleus to regulate cellular genes important for cell proliferation, cell death, and cell migration (PubMed:18158288). The presence of TEAD transcription factors are required for it to stimulate gene expression, cell growth, anchorage-independent growth, and epithelial mesenchymal transition (EMT) induction. Isoform 2: Isoform 2 and isoform 3 can activate the C-terminal fragment (CTF) of ERBB4 (isoform 3). |
| 分子量 | Theoretical: 55 kDa. Actual: 70 kDa. |
| 储存方式 | Store at -20°C or -80°C for 12 months. Avoid repeated freeze-thaw cycles. |
| 运输方式 | Shipping with blue ice. |